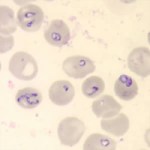
babesia microti
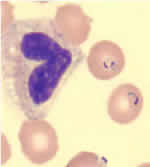

Parasites in the blood supply, and 7 other things you need to know about Babesia 04/27/2012
Posted by thetickthatbitme in TBI Facts.Tags: Babesia, Blood donation, Blood transfusion, health, Malaria, medicine, Mepron, parasite, pregnancy, Rhode Island Blood Center, tick bite
trackback
The fact sheet for Babesia is up today. Here are a few (disturbing) highlights:
1. Babesia is a parasite that attacks red blood cells. There are three ways Babesia spreads: 1) Through the bite of the blacklegged tick (or deer tick, Ixodes scapularis—the same tick that carries Lyme/B. burgdorferi); 2) Through blood transfusions with contaminated donated blood; 3) From mother to baby during pregnancy or childbirth.

A nymphal stage Ixodes scapularis tick (approximately the size of a poppy seed) is shown here on the back of a penny. Credit: G. Hickling, University of Tennessee.
2. The tick that carries Babesia is most likely to infect humans when it’s in its nymphal stage. During this stage, the tick is about the size of a poppy seed. (Maybe this is one reason why Babesia cases are on the rise among older people–they probably have trouble spotting ticks that small!)
3. Many people who have a Babesia infection don’t show any symptoms. When they do show symptoms, they can include fever, chills, sweats, headache, body aches, loss of appetite, nausea, and fatigue. Some develop hemolytic anemia, which causes jaundice and dark urine.
4. Babesia can be deadly if it goes untreated. Here are some possible complications: low and unstable blood pressure; altered mental status; severe hemolytic anemia (hemolysis); very low platelet count (thrombocytopenia); disseminated intravascular coagulation (also known as “DIC” or consumptive coagulopathy), which can lead to blood clots and bleeding; and malfunction of vital organs (such as the kidneys, liver, lungs, and heart).
5. There are two main treatment options for Babesia: a combination of Mepron and Zithromax OR a combination of Clindamycin and Quinine. Children and women who are pregnant should probably not be treated with Mepron.To read more about treatment, go to the Babesia fact sheet.
6. Babesia is sometimes confused with Malaria because they look similar under a microscope and can have similar symptoms. To avoid confusion, doctors should order multiple types of tests for Babesia if patients show symptoms. To read more about available tests, see the fact sheet.
- Babesia parasites in red blood cells on a stained blood smear. (CDC Photo: DPDx). Via CDC.gov.
- Blood smear stained with Giemsa, showing a white blood cell (on left side) and several red blood cells, two of which are infected with Plasmodium falciparum (Malaria) (on right side). Image via CDC.gov.
7. There are 4 identified species of Babesia that infect humans: Babesia microti, B. divergens, B. duncani (WA-1), and MO-1 (unnamed strain). Antibody tests for Babesia are species specific, so if you have B. microti and you are tested for B. duncani, the test will come back negative. This means that patients need to undergo multiple blood tests!
8. Even though Babesia infection is known to be transmitted through blood transfusion (As of Sept. 2011, the CDC has identified 159 cases, and at least 12 of those people have died.), donated blood is not tested for Babesia! Donors are asked to fill out a questionnaire asking whether they have Babesia (not whether they’ve had tick bites or Babesia-like symptoms). In other words, we are relying on patient self-reporting to screen the blood supply for this parasite! (Why they don’t screen out all people who’ve had tick bites is beyond me.) The CDC’s response as to whether they will implement testing of donated blood for Babesia in the future: Maybe. They say they are going to “Monitor reports of tick-borne infection to determine if the disease is spreading to other parts of the country and to identify emerging strains of Babesia that may cause human disease.” In other words, they’re going to wait to see how bad it gets before they do anything about the blood supply. Some organizations like the Rhode Island Blood Center have begun screening blood for Babesia using an experimental test, but this is not mandated by CDC policy.
This might prompt you to ask: What are my local health department, hospitals, and blood donation organizations doing about Babesia in the blood supply?
Have questions or something to add about Babesia? Drop me a comment.
Related articles
- Well, Babs, you’re trickier than I thought (thetickthatbitme.com)

Very informative, comprehensive post. Thank you for taking the time to supply us with all this information. That second image looks like a tiny purple heart is trapped inside. A little life intimating art? *shivers* Yuck!
I always learn something new from you in each post. Thanks for sharing. 🙂
Thanks for reading!
Thanks for your post. The info about this parasite was completely new to me, and a little unsettling… after having a blood transfusion several years ago.
Thank You for taking up this cause, to inform the public about co-infections from Lyme. So many people are suffering and have no where to turn to. You are a very special person.
Thanks, Yvonne!